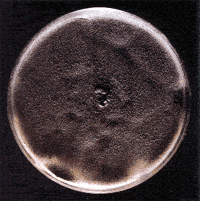

|
INVESTIGACION DE MICOSIS
Muestra:
1- Esputo Ver indicaciones para la recolección
de ESPUTO
2- Lavado broncoalveolar (BAL)
3- Biopsia transbronquial (BTB)
4- Biopsia pulmonar
5- Sangre, médula osea, LCR
6- Material de úlceras orofaríngeas
7- Muestra de pus y/o raspados y/o biopsias de lesiones
8- Punciones
Muestras más apropiadas: 2-3
Método:
Examen microscópico directo.
Cultivo aeróbico en medio selectivo y no selectivo.
Serología.
Significado clínico:
1- Micosis profundas
2- Micosis oportunistas
 1-Micosis profundas: 1-Micosis profundas:
1-a) Sistémicas endémicas son causadas
por:
Histoplasma capsulatum (histoplasmosis): Se encuentra con
mayor frecuencia en las provincias de Buenos Aires, Santa Fe, Entre Ríos
y sur de Córdoba.
El 90% de las infecciones pulmonares primarias son asintomáticas.
Dos factores importantes que determinan el grado de sintomatología
son: la cantidad de inóculo inhalado y el estado inmune del huésped.
La histoplasmosis diseminada se manifiesta en niños menores de
2 años y en inmunocomprometidos.
En adultos inmunocompetentes aproximadamente la incidencia de histoplasmosis
diseminada progresiva es de 1/2000
Utilidad clínica: El diagnóstico de este hongo se
realiza:
En pacientes con SIDA e histoplasmosis diseminada progresiva aguda, el
microorganismo puede ser cultivado en el 80-90 % de los casos de los aspirados
broncoscópicos.
Los cultivos de sangre y médula ósea son positivos en el
50-90%.
En las meningitis asociadas a histoplasmosis los cultivos de LCR son positivos
en el 30-60 % de los casos.
En los pacientes con histoplasmosis diseminada progresiva crónica
los cultivos de las úlceras orofaríngeas casi siempre son
positivos.
Las pruebas serológicas más empleadas son: la fijación
de complemento (FC) e inmunodifusión (ID).
En las regiones endémicas entre el 2 y el 12 % de la población
tiene títulos bajos de anticuerpos contra el H. capsulatum
en la FC.
Títulos aislados de 1/32 son sugestivos de histoplasmosis activa,
títulos de 1/8 y 1/16 son indeterminados, aunque en este intervalo
los títulos deben ser considerados cuidadosamente porque no existe
ninguna correlación entre el nivel de anticuerpos y la gravedad
de la enfermedad, particularmente en pacientes inmunocomprometidos.
La reacción cutánea es de gran valor para estudios epidemiológicos
por mantenerse la reactividad por muchos años.
Paracoccidioides brasiliensis (paracoccidioidomicosis o
blastomicosis sudamericana).
Se ha comunicado sólo en América Latina desde Méjico
hasta la Argentina. Se encuentra en las provincias de Misiones, Formosa,
Chaco, norte de Santa Fe y Entre Ríos.
La paracoccidioidomicosis es una enfermedad granulomatosa y supurativa,
cuyas primeras manifestaciones suelen observarse en la cara y mucosa orofaríngea.
La diseminación es común principalmente hacia las mucosas,
piel, glándulas suprarrenales y sistema reticuloendotelial.
No existe contagio de una persona a otra, afecta más a los hombres
que a las mujeres; es rara en niños y adolescentes.
Utilidad clínica: El diagnóstico se realiza investigando
el hongo en muestras de pus y/o raspados y/o biopsias de lesiones cutáneo/mucosas.
Las pruebas serológicas son útiles no sólo para el
diagnóstico sino también para el seguimiento. La inmunodifusión
demuestra anticuerpos circulantes en el 95% de los casos. Otras pruebas
son: la fijación de complemento, inmunoelectroforesis, contrainmunoelectroforesis
y el ELISA.
La reacción cutánea a la paracoccidioidina es poco confiable.
Coccidioides inmitis (coccidioidomicosis): Se encuentra
en la zona de la precordillera de los Andes, América del Norte,
Central y Sudamérica.
Este hongo tiene predilección por el pulmón y nódulos
linfáticos hiliares. Alrededor del 0,5% de los individuos infectados
por C. inmitis desarrollan enfermedad diseminada.
La diseminación y la enfermedad fatal son mas frecuentes en hombres,
mujeres embarazadas, individuos de raza negra y huéspedes inmunocomprometidos.
Utilidad clínica: El microorganismo puede ser demostrado
por examen directo y cultivo de pus, esputo, aspirado broncoscópico,
líquido sinovial, aspirado de lesiones superficiales del tejido
blando y tejidos profundos resecados.
El cultivo de LCR sólo es positivo en un tercio de los pacientes.
El diagnóstico es usualmente hecho por biopsia o pruebas serológicas.
Las pruebas serológicas que se utilizan son la determinación
de precipitinas séricas, aglutinación con látex,
inmunoensayo enzimático o métodos de inmunodifusión.
En el 75% de los casos los anticuerpos aparecen de una a tres semanas
luego del comienzo de los síntomas de la infección primaria
y desaparecen al cabo de cuatro meses.
Los anticuerpos IgG séricos que fijan complemento aparecen mas
tarde, se encuentran presente en las infecciones primarias más
sintomáticas y pueden durar de 6 a 8 meses.
Las reacciones cutáneas sirven para evaluar la exposición
previa de un paciente que presenta un nódulo pulmonar y para estudios
epidemiológicos.
Blastomyces dermatitidis (blastomicosis): El B. dermatitidis
existe en la naturaleza en climas cálidos y de tierra húmeda.
Se encuentra en Estados Unidos, Africa y Brasil.
Es una enfermedad granulomatosa sistémica. La infección
inicial se produce en pulmón y a menudo es subclínica.
Puede ocurrir diseminación hematógena hacia otros sitios
corporales afectando principalmente la piel, los huesos y el sistema genitourinario.
Han ocurrido casos de blastomicosis cutánea después de una
inoculación casual en el laboratorio, en necropsias y por mordeduras
de perros. No se han documentado casos de transmisión entre personas.
Utilidad clínica: Puede realizarse un diagnóstico
presuntivo por la visualización de la levadura característica
en: pus, esputo, secreciones o cortes histopatológicos, de esta
manera se podría apresurar el comienzo del tratamiento.
El diagnóstico definitivo requiere el crecimiento del microorganismo
recuperado de muestras clínicas.
Las pruebas serológicas no son específicas ni sensibles.
Se utilizan las pruebas de fijación de complemento, inmunodifusión,
radioinmunoensayo, ELISA.
1-b) Micosis sistémicas universales o cosmopolitas causadas
por:
Cryptococcus neoformans (criptococosis): Es un saprófito
en la naturaleza de distribución mundial. Existen cuatro serotipos
diferentes: A, B, C y D. Los serotipos A y D se observan con frecuencia
en las deposiciones de paloma y en lugares de anidación en todo
el mundo. Los serotipos B y C tienen una distribución más
restringida a las áreas tropicales y subtropicales.
La vía de transmisión de la enfermedad es la inhalatoria.
No existe contagio de animales-persona, ni de persona-persona por vía
pulmonar. Se transmite a transplantados que reciben tejidos de donantes
con criptococosis activa.
Este hongo tiene predilección por pulmón y cerebro, pudiendo
encontrarse en hueso, suprarrenales, conjuntiva, pericardio.
Alrededor del 80 al 90% de las infecciones criptococócicas se presentan
en pacientes con SIDA; aunque también individuos carentes de factores
predisponentes pueden desarrollar criptococosis.
La enfermedad del SNC puede presentar lesiones cutáneas en rostro
o cuero cabelludo, siendo frecuentemente los primeros signos de infección.
Utilidad clínica: El diagnóstico puede realizarse
por cultivo de esputo, BAL, LCR, orina, sangre.
Por examen histológico de especímenes de biopsia.
Por examen microscópico del LCR usando tinta china negra que permite
visualizar la cápsula característica.
Pruebas serológicas: detección de antígeno por aglutinación
con látex en LCR.
 2-Micosis oportunistas: 2-Micosis oportunistas:
Los hongos considerados oportunistas del tracto respiratorio inferior
son:
Candida spp.
Aspergillus spp.
Cryptococcus neoformans
Muccor spp, Rhizoppus spp, Absidia spp y Cunninghamella spp.
Sporotrix schenckii
Emmonsia parva
Pneumocystis carinii
Aspergillus niger Aspergillus niger
Candida spp: Candida spp causa neumonía, infección
bronquial, laríngea y epiglotitis.
Utilidad clínica: El hallazgo de levaduras en el esputo
no significa infección por Candida spp.
El diagnóstico definitivo de infección pulmonar por Candida
spp se realiza por biopsia demostrando la invasión fúngica
del tejido y por su recuperación del cultivo de sangre.
Aspergillus spp: Ampliamente distribuídos en el
medio ambiente, las personas con sistema inmune normal usualmente no desarrollan
enfermedad relacionada a Aspergillus spp.
La aspergilosis invasiva se localiza usualmente en el pulmón pudiendo
diseminarse en pacientes con leucemia, linfoma, tumores sólidos,
post-quimioterapia o inmunosuprimidos que generalmente presentan neutropenia.
A. fumigatus y A. flavus son las especies más probablemente
relacionadas con patologías del tracto respiratorio.
Utilidad clínica: El diagnóstico definitivo se realiza
mediante la biopsia de lesiones con cultivo o el examen del tejido.
La broncoscopía con fibra óptica incrementa el aislamiento
del microorganismo en un 55-100%.
La demostración de Aspergillus spp en esputos seriados es
diagnóstico presuntivo de una infección.
Las pruebas serológicas más comúnmente usadas son:
difusión en gel de agar o ELISA. Detectan el 65% y el 80-90% respectivamente
de las infecciones por Aspergillus spp.
Anticuerpos IGE específicos para A. fumigatus han sido reportados
en el 85% de los pacientes con aspergilosis broncopulmonar.
Las pruebas cutáneas y serológicas son usualmente positivas
en personas con asma, aún sin la evidencia de aspergilosis.
Pneumocystis carinii (actualmente se lo considera un hongo):
Es causante de neumonía en pacientes HIV positivos pudiendo producir
diseminación extrapulmonar (menor del 3%) hacia ganglios linfáticos,
bazo, hígado, médula ósea, tracto gastrointestinal,
riñones, otros sitios.
La neumonía por P. carinii ha sido descripta también
en: receptores de aloinjertos de pulmón, riñón, pacientes
con tumores, lactantes debilitados.
Utilidad clínica: El diagnóstico de laboratorio
se basa en el hallazgo microbiológico e histológico del
hongo en el lugar de la infección y/o su detección por métodos
moleculares. No se realiza el cultivo del mismo.
Se emplean diferentes tinciones para identificar P. carinii en
las secreciones respiratorias. Una de las técnicas más utilizadas
es la inmunofluorescencia directa con anticuerpos monoclonales (sensibilidad:
87-96%, especificidad: 90-100%).
En el esputo expectorado raramente es posible hallar P. carinii,
algunas veces se lo encuentra en el esputo inducido.
La mejor muestra es el lavado broncoalveolar (sensibilidad: 85-90%) obtenido
por broncoscopía con fibra óptica.
El cepillo protegido detecta aproximadamente el 40%.
La biopsia transbronquial se utiliza cuando el lavado broncoalveolar es
negativo. Es una técnica más invasiva y presenta complicaciones
(neumotórax, hemorragias). Sensibilidad: 85%.
Otra muestra que debe recolectarse es el esputo post BAL, ya que muchas
veces el BAL puede ser negativo y el esputo post BAL ser positivo para
P. carinii.
En algunas ocasiones puede encontrarse este hongo en el BAL posteriormente
al tratamiento. Esto sugiere una enfermedad persistente o un mayor riesgo
de recurrencia.
Otra técnica es la biopsia de pulmón a cielo abierto. Tiene
una sensibilidad y especificidad del 100%, debe emplearse en el caso que
los métodos anteriores no permitan el diagnóstico.
La técnica de PCR (reacción en cadena de la polimerasa)
tiene una especificidad y sensibilidad del 100% en los BAL de individuos
con SIDA y una sensibilidad del 44% y una especificidad del 25% en los
pacientes con leucemia, linfomas y transplantes.
Cuando se sospecha la presencia de P. carinii extrapulmonar debe
obtenerse muestras del ganglio linfático o del tejido afectado.
Bibliografía:
1-Jacobs D.S., Demott W.R. Grady H. et al. Laboratory Test Handbook,
Edit by Lexi-Comp Inc., Cleveland, United States of America, 4th edition,
1996.
2-Ravel R. Clinical Laboratory Medicine. Clinical application of Laboratory
Data. Mosby editorial, sixth edition, United States of America, 1995
3-Mandel, Bennett and Dolin. Enfermedades infecciosas principios y prácticas.
Editorial Panamericana, 4ª edición; Madrid, España.
Año 1997.
4-Predari S., Barrero L., Lasala B., Savy Vilma. Infecciones de las vías
aéreas inferiores. Asociación Argentina de Microbiología,
Colegio de Bioquímicos de la Provincia de Entre Ríos; Facultad
de Bioquímica y Ciencias Biológicas. Universidad Nacional
del Litoral. Curso de microbiología clínica a distancia.
Agosto de 1999.
5-Bianchini H., Novillo A., Sordelli D. Asociación Argentina de
Microbiología, Colegio de Bioquímicos de la Provincia de
Entre Ríos; Facultad de Bioquímica y Ciencias biológicas.
Universidad Nacional del Litoral. Curso de microbiología clínica
a distancia. Taxonomía y fisiología microbiana. Recolección
y transporte de muestras para el diagnóstico de infecciones. Agosto
de 1997.
6-Costa M. R.M. Diagnóstico micológico. Asociación
Argentina de Microbiología, Colegio de Bioquímicos de la
Provincia de Entre Ríos; Facultad de Bioquímica y Ciencias
Biológicas. Universidad Nacional del Litoral. Curso de microbiología
clínica a distancia. Año 1998.
7-Tietz N. W. Clinical Guide to Laboratory test, edited by W.B. Saunders
Company, third edition. United States of America,1995.
|